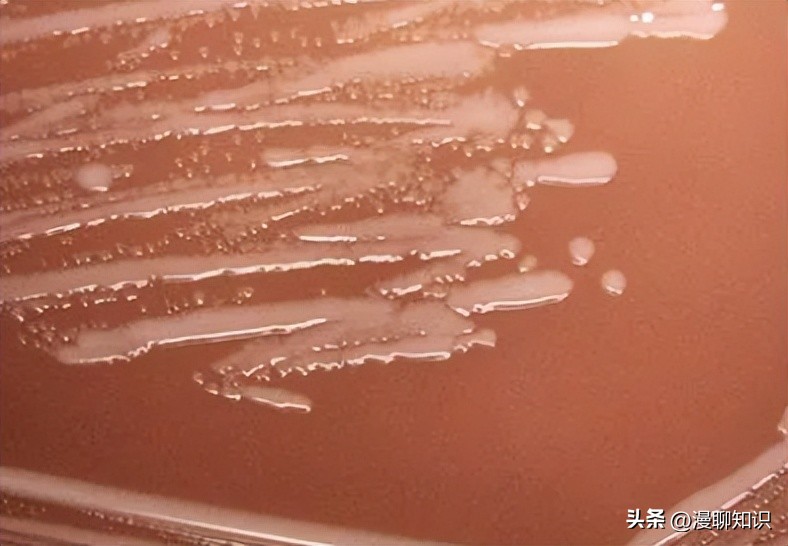
副猪嗜血杆菌是一种巴氏杆菌，其生长依赖于V因子，还有其他的吗
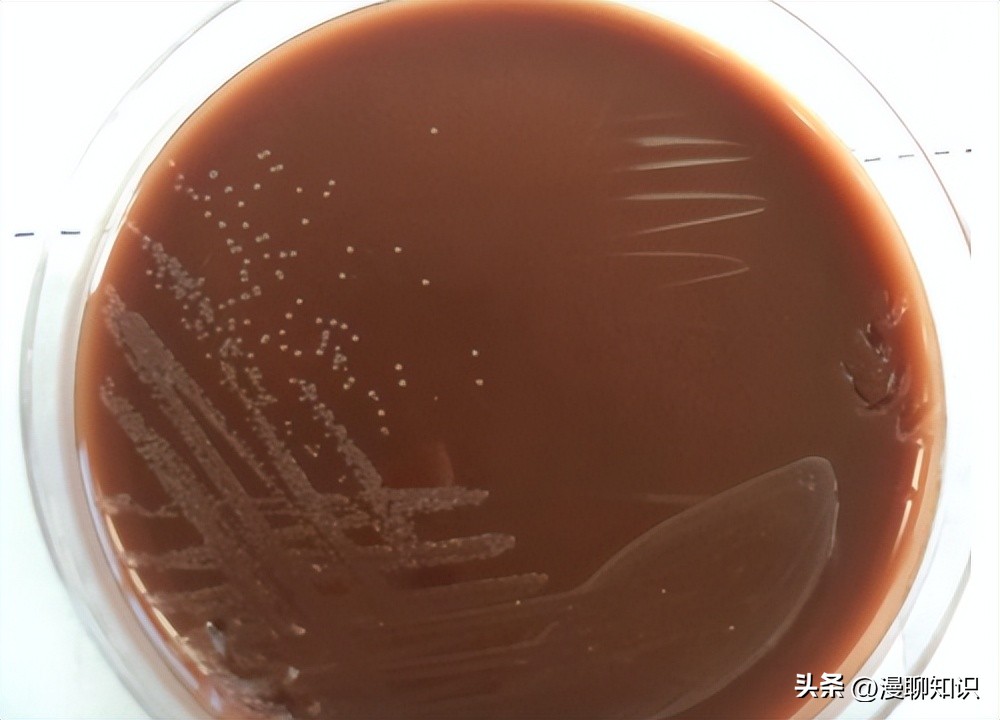
副猪嗜血杆菌是一种巴氏杆菌，其生长依赖于V因子，还有其他的吗
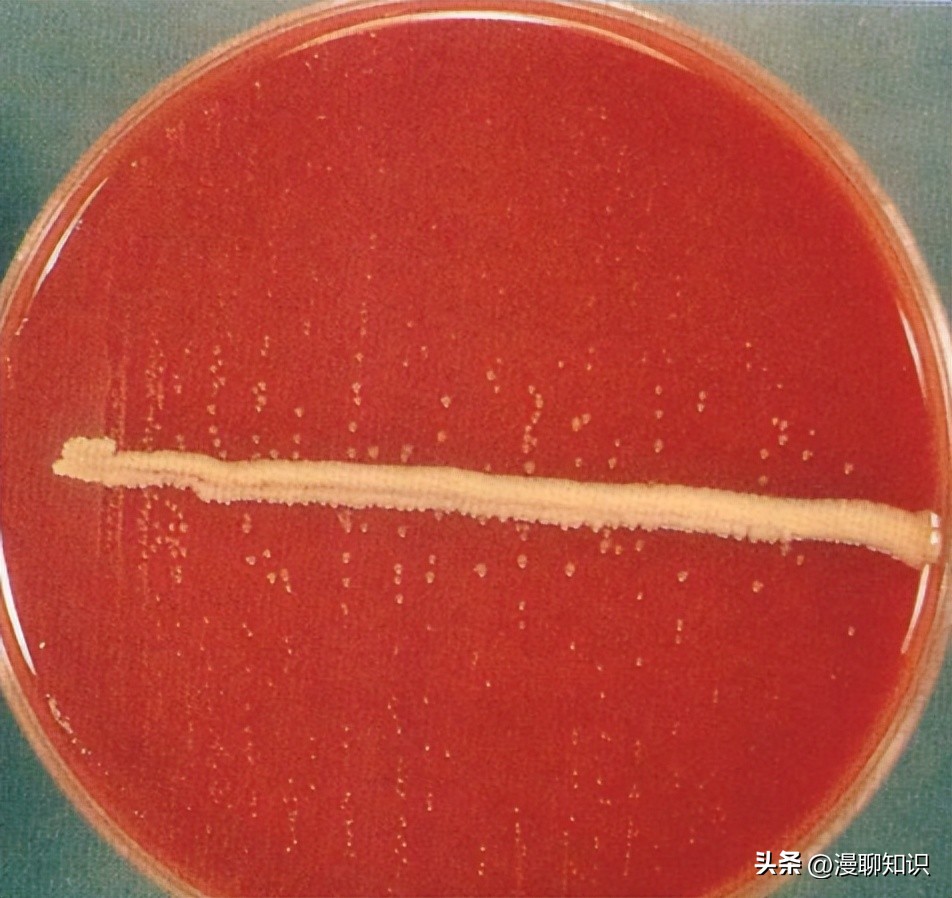
副猪嗜血杆菌是一种巴氏杆菌，其生长依赖于V因子，还有其他的吗

阅读文章前,辛苦您点下右上角的“关注”,方便您讨论分享,持续关注每日优质内容~
副猪嗜血杆菌(Haemophilus parasuis,HPS)是巴氏杆菌(Pasteurellaceae)家族的一员,其生长严格依赖于V因子(烟酰胺腺嘌呤二核苷酸,NAD),而不依赖于X因子(正铁血红素,haemin)。
HPS是一种存在于猪(Sus scrofa)上呼吸道的常见细菌,在特定的环境中,如免疫力低下、应激、饲喂不良等,可引起严重的全身性疾病革拉泽氏病(Glasser's dis‐ease)。
革拉泽氏病以猪严重的上呼吸道感染、纤维性多浆膜炎、多关节炎、脑膜炎为特征,给全球养猪业造成巨大的经济损失。
HPS至少可分为15种血清型。

血清型1、5、10、12、13和14被认为是高毒力的血清型,2、4和15为中度毒性,血清型3、6、7、8、9和11被认为无毒(Ni et al.,2020;Liu et al.,2016)。
在我国,最常见的血清类型是血清4和5型,其次是13、14和12型,还有12%的分离菌株是不可分型的(Cai et al.,2005)。
crp基因编码环磷酸腺苷(cyclic adenosine monophosphate,c AMP)受体蛋白(c AMP receptor protein,CRP),含有675 bp核苷酸,编码225个氨基酸,是大肠杆菌(Escherichia coli) 7个系统调控因子中的一个,在细菌感染过程中,系统调控因子在细菌适应环境变化方面起着至关重要的作用(Zhang et al.,2012a;Basak et al.,2014;Lee et al.,2011)。

研究表明,CRP可以提高大肠杆菌在各种压力条件下的性能,包括渗透压、生物醇应激、氧化应激、低p H值、醋酸及有机溶剂(Geng,Jiang,2015;Zhang et al.,2012b)。
CRP是第一个从大肠杆菌中纯化结晶的原核转录因子,可调节多种基因的表达,与多种毒力因子的表达有关(Yuan et al.,2023;Chen et al.,2020)。
许多革兰氏阴性细菌,包括大菱鲆源杀鱼爱德华氏菌(Edwardsiella piscicida)(Cho et al.,2017)、沙门氏菌(Salmonella)(Chen et al.,2010)、霍乱弧菌(Vibrio cholera)(Zahid et al.,2015)、肺炎克雷伯氏菌(Klebsiella pneumoniae)(Ou et al.,2017)的毒力通过缺失crp基因而减弱。
由于crp基因与毒力密切相关,常被选为研制减毒疫苗的靶点。

前期研究表明,crp基因是副猪嗜血杆菌中比较保守的基因,在各血清型中均有存在,但crp基因在HPS中的功能报道较少,Jiang等(2020;2021)研究显示,crp基因参与HPS生长速度、生物膜形成、应激耐受、血清抗性和铁的利用,但crp基因与4型副猪嗜血杆菌(HPS4)毒力之间的关系仍然需要进一步验证。
本研究采用自然转化法构建HPS4的crp缺失株,对缺失株的生长、抗性及毒力进行了初步研究,旨在为进一步研究crp基因在HPS中的功能提供基础资料。

18 g SPF级雌性Balb/c小鼠(Mus musculus)购自郑州大学实验动物中心。
4型副猪嗜血杆菌(Haemophilus parasuis 4,HPS4)临床分离株HPS4由河南省农业科学院畜牧兽医研究所传染病研究室分离鉴定并保存(王治方等,2019;徐引弟等,2018)。
自杀性质粒p K18mob‐sac B、副猪嗜血杆菌-大肠杆菌(HPS-Escherichia coli)穿梭载体p SHK3-Kan由华中农业大学徐晓娟和蔡旭旺教授馈赠。

参考Gen Bank中HPS4 ZJ0906株全基因组(Gen Bank No.CP005384)序列,用Primer Premier 5设计含有酶切位点及DNA摄取信号序列(DNA up‐take signal sequences,USS)的引物crpu F/crpu R、crp‐d F/crpd R,用于扩增crp上、下游同源臂,crp F/crp R用于扩增crp基因,去掉酶切位点和USS序列的crpuu F/crpdd R用于鉴定crp亲本株与缺失株,参考质粒p SHK3-Kan序列设计Kan F/Kan R用于扩增卡那霉素抗性基因(Kan)。
crp1/crp2位于crp基因内部,用于RT-PCR鉴定crp缺失株,副猪嗜血杆菌crp基因缺失株的构建及验证引物见表1,引物由北京擎科生物科技有限公司合成。
提取HPS4基因组,分别用引物对crpu F/crpu R和crpd F/crpd R扩增714 bp crp基因上游(up)和714 bp下游(down)片段。
PCR反应体系(25μL):10×Taq PCR master mix 13μL,100µmol/L上、下游引物各1.0μL,无菌水5.0μL,DNA模板5μL。
反应条件为:94℃变性5 min;94℃30 s,54℃30 s,72℃30 s,35个循环;72℃延伸5 min。
利用引物Kan F/Kan R从p SHK3质粒中扩增909 bp卡那霉素基因(Kan)。
PCR反应体系(25μL):10×Taq PCR master mix 13μL,上、下游引物(100µmol/L)各1.0μL,无菌水9.0μL,模板1μL。
反应条件为:94℃变性5 min;94℃30 s,55℃30 s,72℃50 s,35个循环;72℃延伸5 min。
利用重叠延伸PCR扩增原理,用引物crpu F/crpd R将这3个片段通过重叠延伸PCR连接,形成重叠片段UKD (crp上游序列+卡那霉素序列+crp下游序列,up+kan+down)。

Bam HⅠ和Eco RⅠ酶切UKD片段,连接到相同酶切的p K18mobsac B质粒,转化DH5α细胞,转化子用50µg/m L Kan固体培养基筛选,阳性质粒命名为p KUKD。
参考闫雪锋等(2021)报道的自然转化法,大量提取重组质粒p KUKD,测定浓度。
将HPS4型临床株复苏,挑取单菌落于5 m L TSB培养基中,37℃振荡培养至OD600值为0.8,取20µL菌液加入8mmol/L c AMP 20µL,混匀,反应10 min,加入2µg重组质粒p KUKD,混匀,反应10 min。
将菌悬液加入到TSA固体培养基上,涂布均匀,37℃孵育5 h。
TSB洗涤细菌,转移到含卡那霉素的TSA固体培养基上,37℃培养24~48 h。
挑取转化子,提取基因组DNA,分别用引物crpuu F/crpdd R、crp F/crp R、Kan F/Kan R扩增UKD序列、crp基因和Kan基因,进一步用RT-PCR方法对缺失株crp基因的转录进行鉴定,提取RNA,反转录成c DNA,crp1/crp2进行扩增。
电泳检测鉴定crp缺失株是否成功构建,并测序验证。

将亲本株HPS4及其缺失株Δcrp挑取单菌落,同时接种TSA固体培养基,37℃培养36 h,观察菌落形态,挑取菌落涂片,进行革兰氏染色镜检,观察菌体形态。
通过扫描电子显微镜观察形态,将HPS4及Δcrp菌液各10 m L,6 000 r/min离心5 min,PBS洗脱3次,1.5 m L 2.5%的戊二醛4℃固定4 h以上,送武汉赛维尔生物科技有限公司进行电镜观察。
HPS4及其crp缺失株Δcrp在TSB液体培养基中37℃培养过夜,用TSB培养基将HPS4、Δcrp的OD600值调整至0.8。
按1∶1 000的接种比例将HPS4、Δcrp接种至新的锥形瓶中,37℃,180 r/min培养。
每隔2 h测定1次菌液的OD600值,至48 h。
设3次重复。
将HPS4和Δcrp以1∶100的比例接种至含有1 m L TSB培养基的玻璃试管中,37℃、150 r/min分别培养24和48 h后,弃掉培养液,甲醇固定,加入2 m L 1%结晶紫溶液染色,室温放置5 min,流水冲洗,干燥后观察结果,同时设TSB培养基为对照。
加入1 m L 33%冰乙酸溶解测定OD630值,3次重复。

为了研究crp基因在副猪嗜血杆菌抵抗外界刺激中的作用,本研究比较了副猪嗜血杆菌临床分离株HPS4、crp缺失株在抵抗外界渗透压应激、热应激和氧化应激上的差异,具体方法参考文献(Huang et al.,2016)。
将过夜培养的HPS4和Δcrp的OD600值调整为0.8。
在900μL细胞悬液中加入100μL 100 mmol/L的KCl,37℃孵育60 min,进行渗透压应激耐受能力检测。
取1 m L稀释的菌悬液在45℃水浴中孵育60 min,检测热应激耐受能力。
在900μL细胞悬液中加入100μL 1 mol/L H2O2,37℃孵育60 min,检测氧化应激耐受能力。
菌株在37℃孵育后,未处理的细胞悬液作为对照。
孵育后,PBS连续稀释,TSA平皿计数测定菌落形成单位(colony forming units,CFU)。
抗应激细胞百分比计算公式为((应激标本CFU/m L)/(对照标本CFU/m L))×100%。

采集健康保育猪血清,0.22μm滤器过滤,-80℃保存备用,56℃水浴30 min。
将100μL OD600值为0.8的HPS4和Δcrp的细菌悬液分别与100μL新鲜血清和灭活猪血清混合。37℃水浴中孵育1 h。
连续稀释10倍,涂TSA平板,37℃培养36 h,连续10倍稀释,根据预试验OD600值与菌量的关系,取合适的稀释度涂平板,记录HPS4和Δcrp在新鲜血清和灭活血清处理1 h后菌落的数量。
根据存活率=(新鲜血清(CFU/m L)/热处理血清(CFU/m L))×100%计算结果。
将HPS4和Δcrp培养过夜,OD600调整为0.8。
然后将50µL稀释的HPS4和Δcrp细胞悬液加入含100µmol/L 2,2'-联吡啶(2,2'-dipyridine,BIP)的5 ml新鲜TSB培养基中,造成铁限制环境,同时在限铁培养基中加入100µmol/L Fe SO4作为铁源,以新鲜的正常TSB培养基为对照。
37℃震荡培养12 h后测定OD600。

选取18 g左右SPF级Balb/c小鼠104只,随机分成13组(HPS4和Δcrp菌株各6组,空白对照1组),每组8只。
将过夜培养的HPS4和Δcrp的OD600值调整为0.8。
以1∶100的比例接种TSB,培养至稳定期前期,生理盐水2倍稀释成6个不同的梯度,每只小鼠腹腔注射0.5 m L,每个梯度注射8只,对照注射生理盐水,同时原液10倍稀释,进行活菌计数。
观察记录小鼠的发病和死亡情况,观察14 d,死亡小鼠取肝脏、肺脏、心脏、脾脏、肾脏和脑抹片观察,并且接种TSA培养基。
肝脏、肺脏用多聚甲醛固定后送武汉赛维尔生物科技有限公司进行病理切片。
根据Reed-Muench法计算LD50。

利用Graph Pad Prism 8.0进行方差分析和t检验,P≥0.05为差异不显著,P<0.05为差异显著,P<0.01为差异极显著。
通过自然转化法将重组自杀性质粒p KUKD转入HPS4,PCR鉴定结果所示,引物crpuu F/crpdd R鉴定UKD,缺失株片段长2 337 bp,亲本株片段长2 103 bp,引物crp F/crp R鉴定crp基因,缺失株未扩增到675 bp的crp基因片段,亲本株能扩增到。
引物Kan F/Kan R鉴定Kan基因,缺失株扩增到909 bp的Kan基因,亲本株未扩增到。
RT-PCR结果,亲本株检测到crp基因的转录,而缺失株未检测到,证明缺失株构建成功。